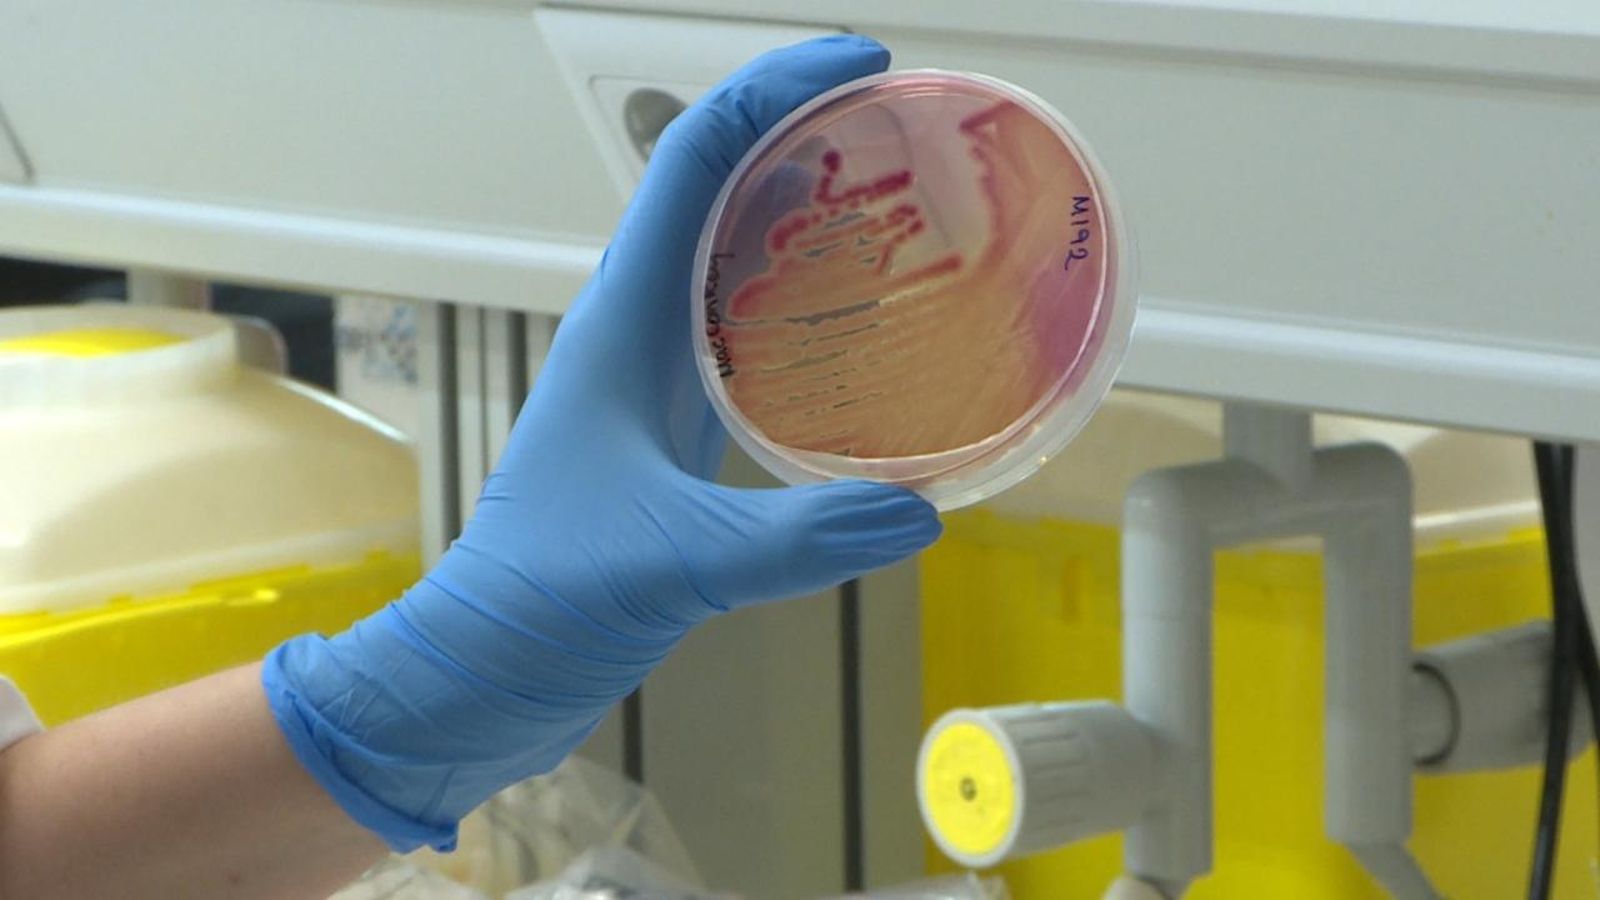
Imatge d'arxiu d'unes mostres de bacteris en un laboratori

Retiren del mercat diversos lots d’un maquillatge corrector per la presència d'un bacteri
Segons l’Aemps, el bacteri pot presentar risc per a persones amb problemes de salut o amb el sistema immunitari afeblit

L'Agència Espanyola de Medicaments i Productes Sanitaris (Aemps) ha retirat aquest dimecres i ha cessat la comercialització de diversos lots del maquillatge corrector Essence Camouflage+ Matt per la presència d'un bacteri que pot representar riscos per a persones amb problemes de salut o amb el sistema immunitari afeblit.
En una nota de premsa, l’Aemps ha informat de la retirada dels lots afectats (ODBCB, ODBCA i OCBCA) per la contaminació del microorganisme Pseudomonas aeruginosa, i ha demanat als usuaris que, si tenen alguna unitat d'aquests lots, es dirigisquen a l'establiment on el van adquirir per a devolució.
L'empresa responsable de la fabricació —Cosnova GmbH, situada a Alemanya— ha publicat una nota en el seu web on informa els usuaris que deixen d'usar aquest producte, el destruïsquen o el tornen al comerç.
La distribuïdora a Espanya (Future Cosmetics. SL) ha comunicat a l'Aemps l'inici de la retirada de totes les unitats posades en el mercat dels lots afectats. Per la seua banda, l'agència ha informat sobre aquestes mesures a les autoritats sanitàries de les comunitats autònomes, per a la difusió i actuacions oportunes.